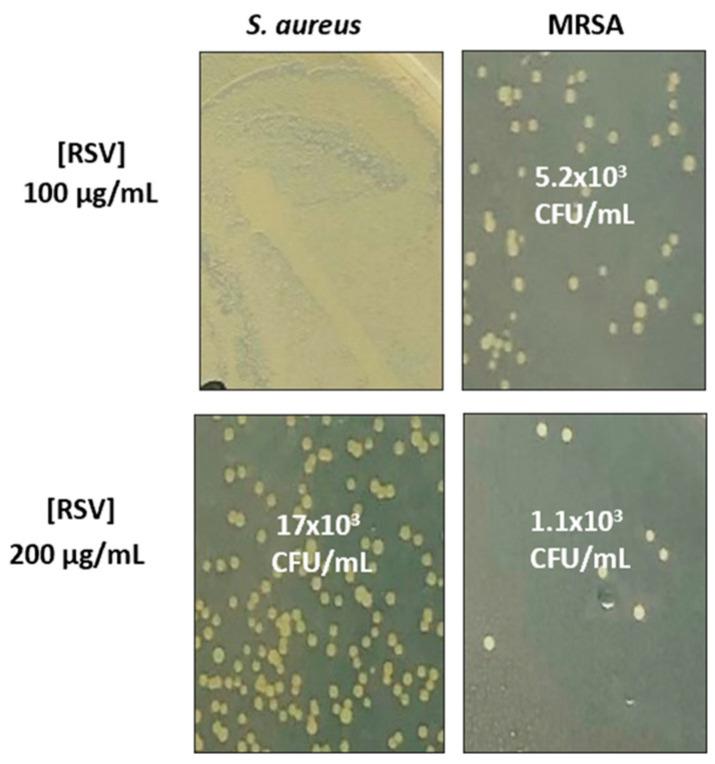
https://cdn.ncbi.nlm.nih.gov/pmc/blobs/7ecb/10741626/7ee27ba6ab49/biomolecules-13-01794-g008.jpg

白藜芦醇和载白藜芦醇半乳糖化脂质体对 和 MRSA 的抗黏附及细胞壁损伤作用。
Resveratrol and Resveratrol-Loaded Galactosylated Liposomes: Anti-Adherence and Cell Wall Damage Effects on and MRSA.
机构信息
Department of Chemistry and Technology of Drug, Sapienza University of Rome, Piazzale Aldo Moro 5, 00185 Rome, Italy.
Institute for Biological Systems of Italian National Research Council (ISB-CNR), Area della Ricerca di Roma 1, Via Salaria Km 29,300, 00015 Monterotondo, Italy.
出版信息
Biomolecules. 2023 Dec 14;13(12):1794. doi: 10.3390/biom13121794.
Antibiotic resistance due to bacterial biofilm formation is a major global health concern that makes the search for new therapeutic approaches an urgent need. In this context,, -resveratrol (RSV), a polyphenolic natural substance, seems to be a good candidate for preventing and eradicating biofilm-associated infections but its mechanism of action is poorly understood. In addition, RSV suffers from low bioavailability and chemical instability in the biological media that make its encapsulation in delivery systems necessary. In this work, the anti-biofilm activity of free RSV was investigated on and, to highlight the possible mechanism of action, we studied the anti-adherence activity and also the cell wall damage on a MRSA strain. Free RSV activity was compared to that of RSV loaded in liposomes, specifically neutral liposomes (L = DOPC/Cholesterol) and cationic liposomes (LG = DOPC/Chol/GLT1) characterized by a galactosylated amphiphile (GLT1) that promotes the interaction with bacteria. The results indicate that RSV loaded in LG has anti-adherence and anti-biofilm activity higher than free RSV. On the other side, free RSV has a higher bacterial-growth-inhibiting effect than encapsulated RSV and it can damage cell walls by creating pores; however, this effect can not prevent bacteria from growing again. This RSV ability may underlie its bacteriostatic activity.
由于细菌生物膜形成而导致的抗生素耐药性是一个主要的全球健康问题,使得寻找新的治疗方法成为当务之急。在这种情况下,白藜芦醇(RSV)作为一种多酚天然物质,似乎是预防和消除生物膜相关感染的一个很好的候选物,但它的作用机制尚不清楚。此外,RSV在生物介质中存在生物利用度低和化学稳定性差的问题,这使得必须将其封装在递药系统中。在这项工作中,研究了游离 RSV 对 和 的抗生物膜活性,为了突出其可能的作用机制,我们研究了抗黏附活性以及对耐甲氧西林金黄色葡萄球菌(MRSA)菌株的细胞壁损伤。将游离 RSV 的活性与负载在脂质体中的 RSV 进行了比较,特别是负载在中性脂质体(L = DOPC/胆固醇)和阳离子脂质体(LG = DOPC/胆固醇/GLT1)中的 RSV,后者由一种促进与细菌相互作用的半乳糖基两亲物(GLT1)进行了修饰。结果表明,负载在 LG 中的 RSV 具有比游离 RSV 更高的抗黏附和抗生物膜活性。另一方面,游离 RSV 对细菌生长的抑制作用强于包封的 RSV,并且可以通过形成孔来破坏细胞壁;然而,这种作用并不能阻止细菌再次生长。RSV 的这种能力可能是其抑菌活性的基础。